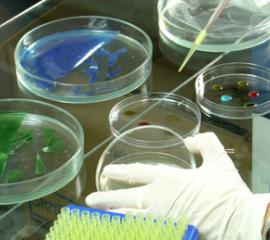

Noticias
Pasantía de investigadora de la Facultad Tecnológica en U. de Buenos Aires afianza vínculos con pares trasandinos
Pasantía de investigadora de la Facultad Tecnológica en U. de Buenos Aires afianza vínculos con pares trasandinos
 Facultad de Ingeniería se adjudica proyecto con miras a transformar sus carreras en unidades de “clase mundial”
Facultad de Ingeniería se adjudica proyecto con miras a transformar sus carreras en unidades de “clase mundial”
 Seminario sobre gestión de residuos y reciclaje convoca a expertos internacionales y a representantes de 55 comunas
Seminario sobre gestión de residuos y reciclaje convoca a expertos internacionales y a representantes de 55 comunas
 Rectores de Universidades del Estado abordan reformas a la Educación Superior con candidata Michelle Bachelet
Rectores de Universidades del Estado abordan reformas a la Educación Superior con candidata Michelle Bachelet
 Seminario internacional reunió a expertos y autoridades en torno a los desafíos de la gestión de residuos
Seminario internacional reunió a expertos y autoridades en torno a los desafíos de la gestión de residuos
 Programa Estudios de Gobierno investigó percepciones de funcionarios públicos sobre la Ley de Transparencia
Programa Estudios de Gobierno investigó percepciones de funcionarios públicos sobre la Ley de Transparencia
 Académicos del Departamento de Educación valoran propuestas de candidata Bachelet para sistema universitario
Académicos del Departamento de Educación valoran propuestas de candidata Bachelet para sistema universitario
 Radio U. de Santiago celebra su mes aniversario con inédita campaña para fidelizar y sumar auditores de la comunidad universitaria
Radio U. de Santiago celebra su mes aniversario con inédita campaña para fidelizar y sumar auditores de la comunidad universitaria
 Experto en inclusión social en educación reitera su apoyo a cambios a la PSU e incorporación del Ranking de Notas
Experto en inclusión social en educación reitera su apoyo a cambios a la PSU e incorporación del Ranking de Notas
 Investigadores proponen nueva metodología orientada a la medición de vulnerabilidad socio territorial
Investigadores proponen nueva metodología orientada a la medición de vulnerabilidad socio territorial
 Centro de Investigación e Innovación en Educación inicia cursos para formación de tutores e-learning
Centro de Investigación e Innovación en Educación inicia cursos para formación de tutores e-learning
 Vicerrectoría Académica reitera invitación a la comunidad universitaria a participar en proceso de actualización del Modelo Educativo
Vicerrectoría Académica reitera invitación a la comunidad universitaria a participar en proceso de actualización del Modelo Educativo
 Facultad de Ingeniería lanza proyecto de diseño de plan estratégico que posicionará sus carreras a nivel mundial
Facultad de Ingeniería lanza proyecto de diseño de plan estratégico que posicionará sus carreras a nivel mundial
 Innova Chile de Corfo lanza concurso orientado a la comercialización de tecnología en mercados globales
Innova Chile de Corfo lanza concurso orientado a la comercialización de tecnología en mercados globales
 Rectores de universidades estatales entregaron al Senado sus propuestas para un nuevo sistema de Educación Superior
Rectores de universidades estatales entregaron al Senado sus propuestas para un nuevo sistema de Educación Superior
 Investigadora lidera estudio sobre psicosis que permitirá rehabilitación y reinserción social de pacientes
Investigadora lidera estudio sobre psicosis que permitirá rehabilitación y reinserción social de pacientes
 Economista de la FAE descarta que la creación de una AFP estatal solucione problemas del sistema de pensiones
Economista de la FAE descarta que la creación de una AFP estatal solucione problemas del sistema de pensiones
 Facultad de Humanidades celebra 69° aniversario y anuncia la apertura de la carrera de Ciencias Políticas
Facultad de Humanidades celebra 69° aniversario y anuncia la apertura de la carrera de Ciencias Políticas
 Presidente de la República, rectores, artistas y auditores saludan a Radio U. de Santiago en su 54° aniversario
Presidente de la República, rectores, artistas y auditores saludan a Radio U. de Santiago en su 54° aniversario
 Consejo de Rectores hizo llamado a reconstituir espacios de diálogo y reflexión para restablecer actividades académicas
Consejo de Rectores hizo llamado a reconstituir espacios de diálogo y reflexión para restablecer actividades académicas
 Censo TIC: Académico plantea que la tecnología es relevante cuando se integra a un modelo pedagógico
Censo TIC: Académico plantea que la tecnología es relevante cuando se integra a un modelo pedagógico
 Rectores expresan solidaridad con la comunidad de la Universidad de Chile por actos de represión policial
Rectores expresan solidaridad con la comunidad de la Universidad de Chile por actos de represión policial
 Rector Zolezzi visita Liceo Lastarria e invita a sus alumnos a conocer y postular a la U. de Santiago de Chile
Rector Zolezzi visita Liceo Lastarria e invita a sus alumnos a conocer y postular a la U. de Santiago de Chile
 Académicos de la FAE desarrollan un índice orientado a acreditar la eficiencia económica de universidades
Académicos de la FAE desarrollan un índice orientado a acreditar la eficiencia económica de universidades
 Con gran éxito se realizó jornada sobre el "Mundo Clásico” que reunió a estudiosos de distintas disciplinas
Con gran éxito se realizó jornada sobre el "Mundo Clásico” que reunió a estudiosos de distintas disciplinas
 Departamento de Tecnologías Industriales impulsa programa que incentiva cultura de la propiedad intelectual e industrial
Departamento de Tecnologías Industriales impulsa programa que incentiva cultura de la propiedad intelectual e industrial
- ‹ anterior
- 189 de 466
- siguiente ›

























